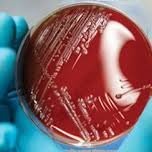
Mehar jabeen

Company Details
- Employees
- 36
- Founded
- 2015
- Address
- Plot No K-219-A, Site, Super Highway Phase Ii, Karachi. Pakistan., Karachi,sindh,sindh,pakistan
- Industry
- Pharmaceutical Manufacturing
- NAICS
-
Pharmaceutical and Medicine ManufacturingMedicinal and Botanical ManufacturingPharmaceutical Preparation ManufacturingIn-Vitro Diagnostic Substance ManufacturingBiological Product (except Diagnostic) Manufacturing
- Website
- https://winthrox.com/
- Keywords
- Representative jobs.
- HQ
- Karachi, Sindh, Sindh